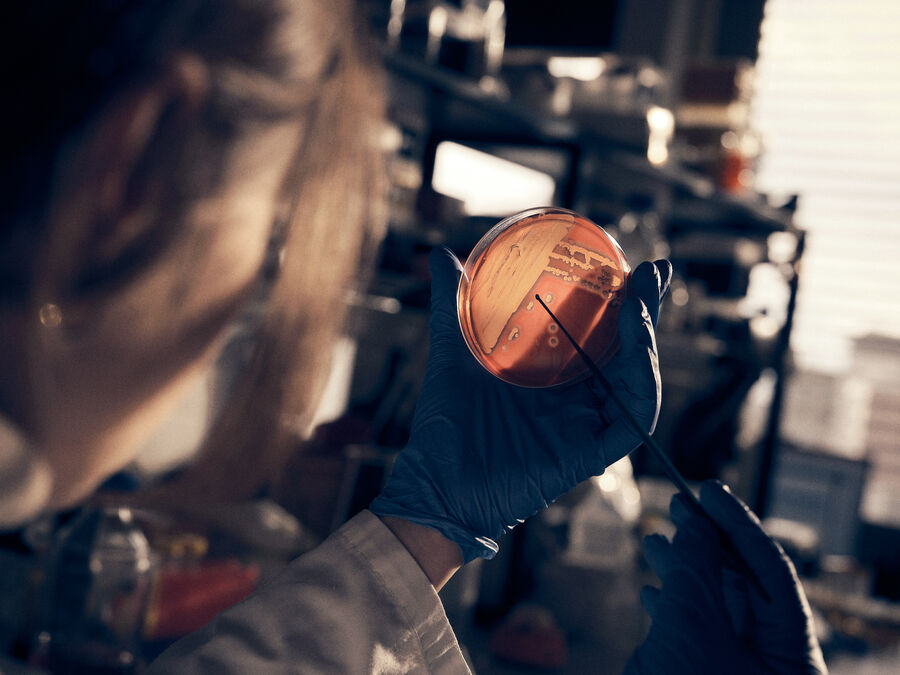

Industrie
Zwischen Licht und Atem
Licht berührt Gesichter, leise, konzentriert. Blicke durch Glas, Hände in Handschuhen, präzise und behutsam zugleich. Zwischen Schatten und Strahlen verdichtet sich Zeit. Vertrauen liegt in Gesten, Ernsthaftigkeit in jeder Bewegung. Und da ist das Leichte: ein Lächeln im Korridor, ein Moment Nähe. Präzision und Menschlichkeit greifen ineinander – Forschung und Fürsorge im gleichen Takt. Ein stiller Herzschlag aus Licht und Arbeit.